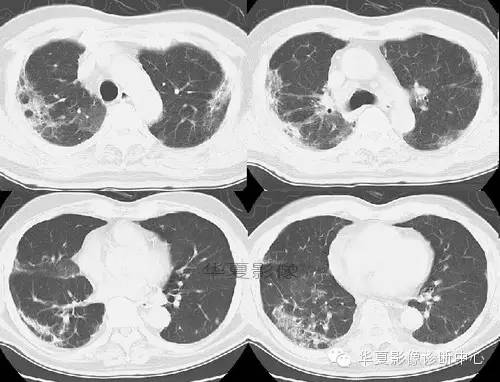
【病例】慢性嗜酸细胞性肺炎1例CT影像表现

【病例】慢性嗜酸细胞性肺炎1例CT影像表现
发布时间:2022-10-22
发布时间:2022-10-22
患者,女,50岁。干咳、进行性呼吸困难、发热和体重减轻。

CT图像特点:双侧胸膜下片状、蜂窝状改变,肺内长条索状影向胸膜延伸。
结果:慢性嗜酸细胞性肺炎
点评:本病是寄生虫(钩虫、蛔虫等)和药物(呋喃妥因等)所致的变态反应,为肺部嗜酸粒细胞浸润的一种消耗性疾病。 慢性嗜酸粒细胞性肺炎:患者多见于中青年女性,发热、体重减轻、盗汗。咳嗽多粘痰,伴气急和咯血。周围血嗜酸粒细胞比例多在20%-70%。肺间质、肺泡和细支气管内有白细胞浸润,主要为成熟嗜酸粒细胞,少量组织细胞和淋巴细胞,肺泡中可见细胞内含有嗜酸性颗粒和尖棱结晶的多核巨细胞,此为本病的病理特点。有些肺小血管,主要是肺静脉有血管炎,有时见多核巨细胞及嗜酸肉芽肿。
胸部X片显示不呈段或叶性分布的周围片状阴影,常为双侧分布。糖皮质激素治疗后48h内症状和胸片可迅速消失。在同一局部可反复发生,数年后变为纤维化或蜂窝状改变。 糖皮质激素治疗效果显著,常可恢复正常,因停药较易复发,故全疗程需在一年以上。
相关知识:慢性嗜酸性粒细胞性肺炎(chrinic eosinophilic pneumonia,CEP)又称迁延性肺嗜酸性粒细胞浸润症、慢性嗜酸性肺炎,由Carrington在1969年首次描述。病程及肺部X线表现常较迁延,往往超过1个月,症状也较单纯性肺嗜酸性粒细胞浸润症(PIE)为重。病因尚不清楚,可能与单纯性肺嗜酸性粒细胞浸润症相似。有人认为它是L?ffler综合征的一种类型。寄生虫中以钩虫和蛔虫所致者多见,药物中以呋喃妥因多见,其他病因还有球孢子菌病,布鲁杆菌病等。不少病人有过敏体质,但其真正病因不明。
临床表现: 近半数患者有既往过敏疾病史,如过敏性鼻炎、鼻息肉等。约2/3患者以哮喘为首发症状,或与其他肺部症状同时出现。起病较缓,常见症状有咳嗽、低热、盗汗、体重减轻、乏力等,少数病人可有咯血。后期常有进行性气急,与哮喘发作有关。半数以上患者体检可以发现喘鸣,并可听到细湿啰音。
治疗:糖皮质激素为首选治疗,常用泼尼松30~40mg/d,治疗1~2天后气急、喘鸣、咳嗽等症状即可好转,所有临床症状在治疗2~3周后可完全消失,肺部X线异常约在2个月内恢复正常。考虑到此病停药后容易复发,尤其疗程短于3个月者,故多主张肾上腺皮质激素治疗应维持6~12个月。少部分病人需长期维持治疗,一般用泼尼松2.5~10mg/d。
补充病例:
2006/04/24



2006/05/22



上一篇:主动脉壁内血肿
下一篇:【病例】胰胸瘘2例影像表现